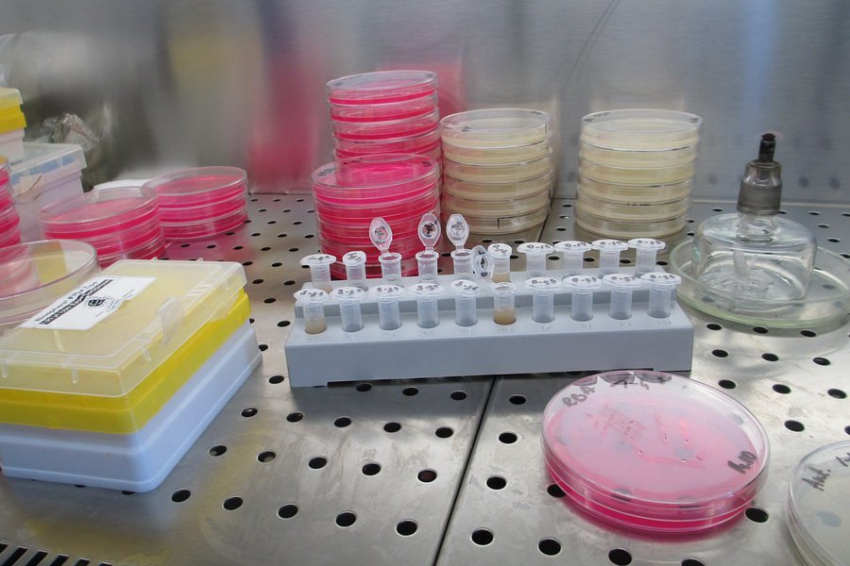

Мутации птичьего гриппа: новые свойства вируса обнаружены в Техасе
Американские исследователи выявили серьезные изменения в геноме вируса птичьего гриппа, выделенного от пациента в Техасе. Специалисты из Texas Biomed провели детальный анализ генетического материала вируса, который показал наличие девяти значимых мутаций.
Научная группа изучила различия между вирусными штаммами, полученными от человека и крупного рогатого скота. В человеческом варианте вируса обнаружились уникальные генетические изменения, отсутствующие в образцах от животных. Это указывает на то, что мутации возникли непосредственно во время инфицирования человеческого организма.
Лабораторные исследования на мышах продемонстрировали повышенную патогенность человеческого штамма. Особую тревогу вызывает способность мутировавшего вируса проникать в ткани головного мозга и размножаться там в значительных количествах.
За последний год вирус H5N1 существенно расширил круг своих хозяев. Если раньше он поражал преимущественно диких и домашних птиц, то теперь активно заражает различных млекопитающих, включая крупный рогатый скот. В 2024 году зафиксированы множественные случаи заболевания среди работников животноводческих ферм в разных штатах США.
Хотя большинство заболевших людей перенесли инфекцию в легкой форме, специалисты обеспокоены возможностью дальнейшей эволюции вируса. Положительным моментом остается сохранение эффективности существующих противовирусных препаратов в отношении как человеческого, так и животного штаммов вируса.
Обсудим?
Смотрите также: